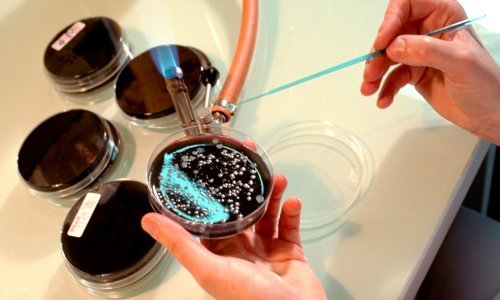

Oporbeni zastupnici upozorili su u srijedu da su pojava zaraze legionelom u KBC-u Zagreb i reakcije nadležnih pokazali da se zdravstvenim sustavom ne upravlja dobro te poručuju da je komuniciranje u javnosti bilo katastrofalno za što su odgovorni i uprava i ministar.
„Pojava legionele u bolničkim sustavima nije nešto što se ne događa, to je relativno redovita pojava po bolničkim i većim sustavima, a kada je dodatno u pitanju i obnova bolnice, onda je rizik za pojavu te bolesti još veći. Od pitanja kada je javnost za to doznala, važnije je kada se otkrila legionela, je li to bilo na vrijeme i kako se postupalo nakon toga i je li se postupalo pravovremeno po protokolu epidemiološke službe, kojoj se to odmah mora prijaviti”, odgovorila je predsjednica saborskog Odbora za zdravstvo Ivana Kekin (Možemo!) na pitanje ima li dojam da se pokušala zataškati pojava legionele.
Čudi se izjavi ministra Vilija Beroša da nije ništa znao o tome jer on vodi cijeli sustav, a ravnateljstvo KBC-a tvrdi da je obavijestilo Hrvatski zavod za javno zdravstvo, a ako su ga oni obavijestili, pitanje je gdje su šumovi u kanalu, zapitala je.
„Je li za ovu infekciju odgovoran ravnatelj KBC-a tek treba utvrditi, a ključno je je li KBC Zagreb sve radio po predviđenim protokolima, a ako se utvrdi da nije, onda možemo govoriti o odgovornosti KBC-a”, ustvrdila je.
Ocijenila je da je ovo još jedan dobar simptom da hrvatski zdravstveni sustav nije povezan, ne upravlja se dobro i stvari ne idu glatko.
Kazala je i da se puno govori o tome da su oboljeli i preminuli teški pacijenti, što je točno, ali, naglašava, oni su bili na intenzivnom odjelu da bi preživjeli, a ne da bi dobili legionelu.
„Treba utvrditi i je li se mogla spriječiti zaraza ili je doista u pitanju nešto što se nije moglo spriječiti”, zaključila je Kekin.
SDP-ov Željko Jovanović smatra da u ovom slučaju nema dileme da se pokušala zataškati zaraza.
Za to, kaže, postoji, više razloga, a jedan od njih je da upravo traje izbor za novog ravnatelja KBC Zagreb, a siguran je da aktualni ravnatelj Ante Ćorušić sigurno nije htio da ova tragična priča utječe na njegov imidž uspješnog ravnatelja.
Usto, dodaje, tragično je da se smrt troje ljudi opravdava da su ionako bili bolesni, a, zapitao je, znači li to da ljude s malignim bolestima ne treba liječiti nego ih pustiti da umru.
„Način na koji je on komunicirao ovu priču je katastrofalan i tražimo odgovornost za to, kao i za način postupanja nakon što se doznalo za legionelu jer se trebali izaći u medije i početi s postupcima osiguravanja da se takav incident ne bi ponovio”, poručio je Jovanović.
Ako je ravnatelj sve to znao, ništa nije radio, nije informirao svog ministara, nije informirao javnost. Lako se hvaliti u spisima, a u kriznom komuniciranju treba se upozoriti na problem kako bi se znalo da ste se s tim problemom uspješno nosili. Oni to nisu učinili i ja inzistiram da se provede detaljna inspekcija da vidimo što se dogodilo i da se to ne bi više ponovilo, istaknuo je.
Dodavo je da ugrožavanje javne sigurnosti, nečinjenje, ugrožavanje pacijenata, liječnika, sestara, svih zaposlenih u KBC-u predstavlja možda i kaznenu odgovornost.
Sustav zdravstva u Republici Hrvatskoj kojim upravlja HDZ ne vodi se dobro i za to odgovornost snosi uprava KBC-a, na čelu s ministrom zdravstva koji kaže da ništa nije znao, zaključio je Jovanović.